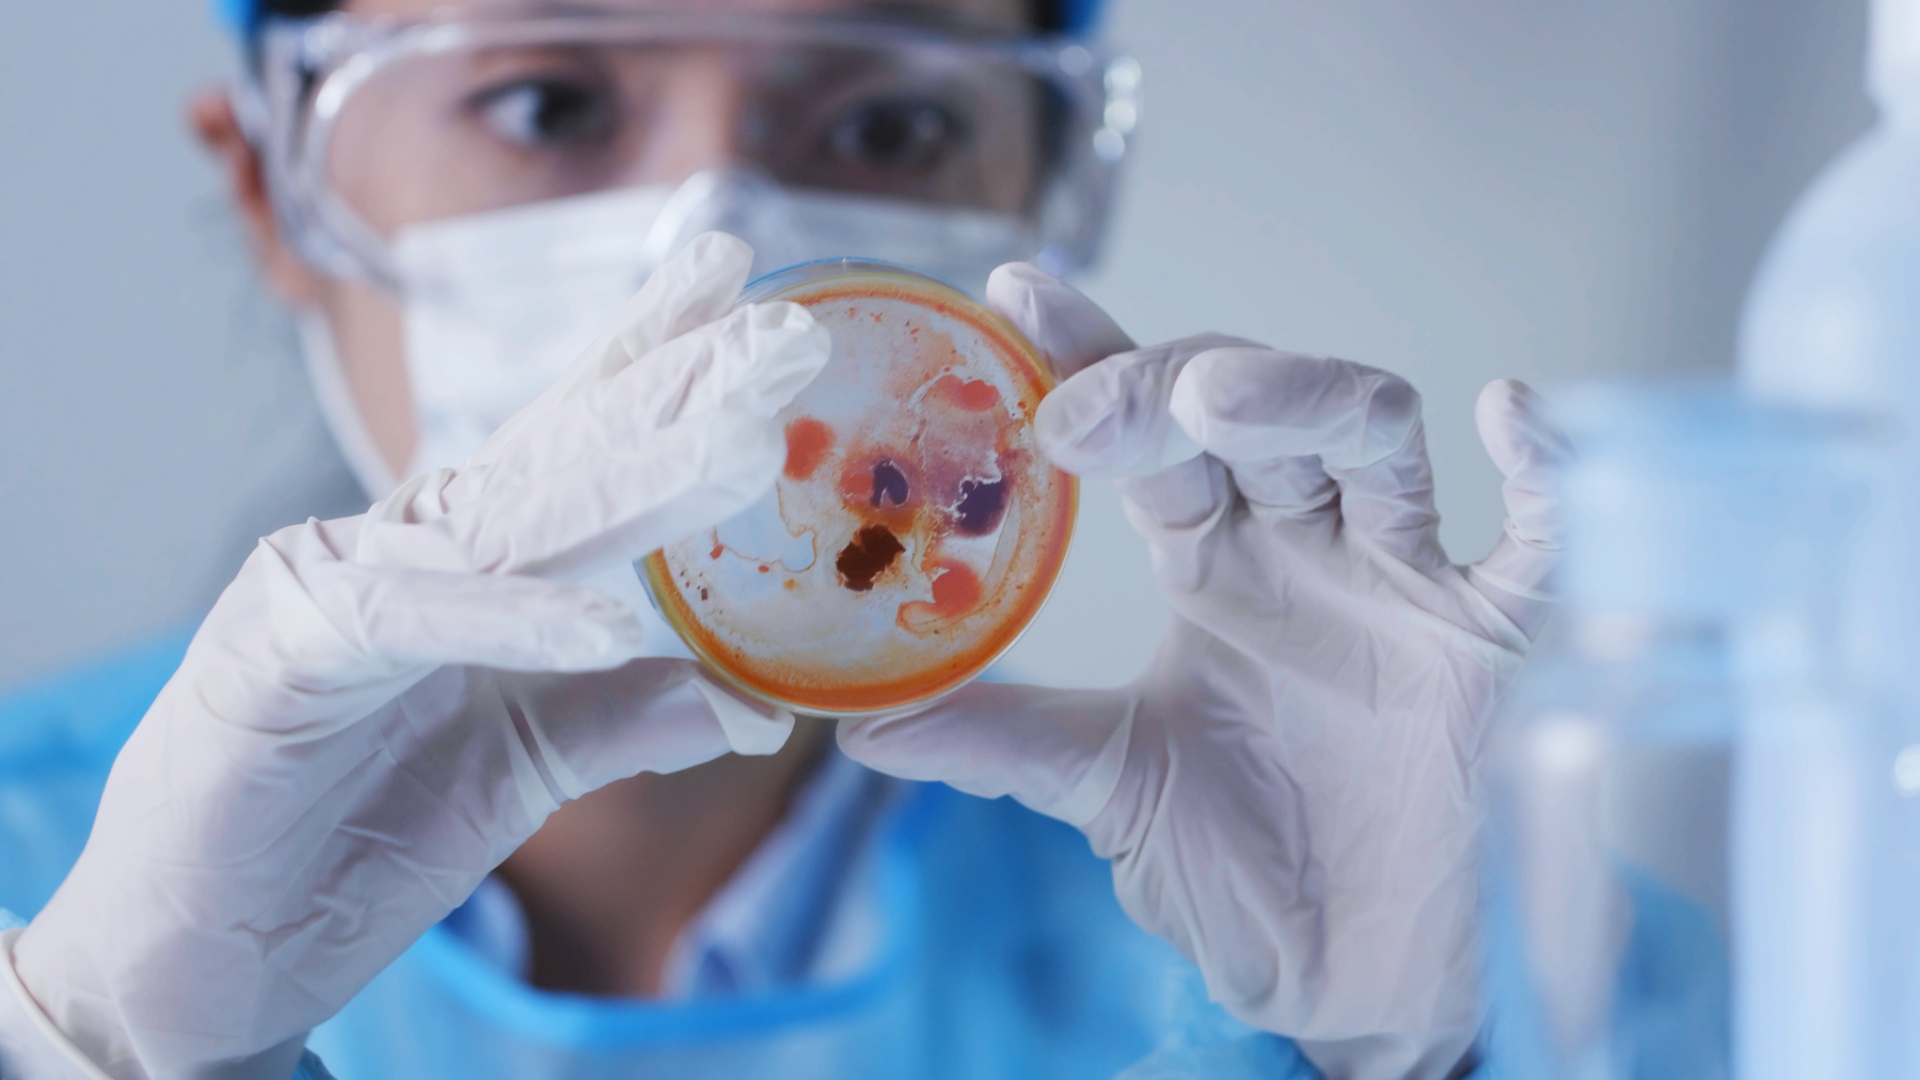

Dadbox sapi de cv. Bitso sapi de cv.
Mexico E Amp P Reform A Marathon Not A Sprint Jaguar Ceo Says
Play business sapi de cv. Bitso sapi de cv. Because it is part of the company name. José antonio rivero larrea is a businessperson who has been the head of 12 different companies and holds the position of chairman of gfm resources ltd chairman for compañia minera autlan sa de cv chairman for metallorum holding sapi de cv a subsidiary of compañia minera autlan sa de cv chairman at grupo de ferrominero sa chairman for allegro airlines chairman president at. Is the way i translate it in parenthesis while retaining the sa. What is measured can be transformed. Buy and sell bitcoin and other cryptocurrencies from 100 pesos.
To accomplish this goal our. Inkoo mind business inspiration sapi de cv broadcast media fracc rincón de santa maría nuevo león 242 followers inkoo. Q pagos sapi de cv. Hova networks sapi de cv 177 followers on linkedin hova networks constructs an infrastructure that offers our users a unique experience of unified communications. March 9 2014 by arbiec group sapi de cv drink wheel play the drink wheel with your friends and have a good time enjoying irish drinks on st. Patricks dayspin the wheel to decide which.
In 2005 mexicos federal congress enacted a new ley del mercado de valores lmv which is mexicos securities act29 the lmv became effective on june 28 200630 and introduced a new type of business entity the sociedad anónima promotora de inversión sapi31 sapis cannot be publicly traded. Bitso sapi de cv. Dadbox sapi de cv. Make your business a reality. View the catalog of haas machines through augmented reality. Bitso sapi de cv.
In some documents you can find it written out especially in the companys articles of incoporation or modifications thereto. Continue reading the main story. Dadbox sapi de cv. Buy and sell bitcoin and other cryptocurrencies from 100 pesos.